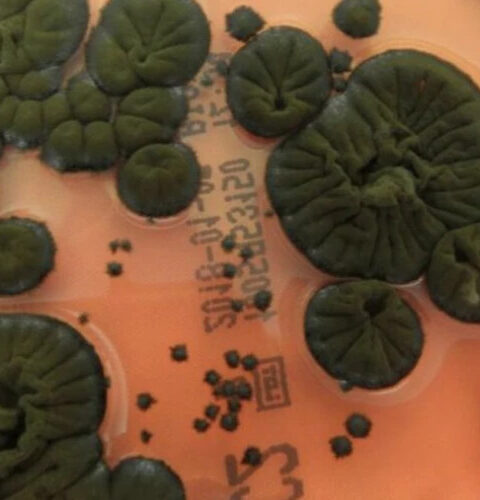
Учёные обнаружили уникальный гриб в Чернобыле, способный использовать ионизирующее излучение

Саркофаг Чернобыльской АЭС в опасности из-за ракетных и дроновых ударов
Защитное сооружение над четвёртым энергоблоком Чернобыльской атомной электростанции остаётся уязвимым в условиях продолжающихся рисков ракетных и дроновых ударов. Об этом заявил директор станции Сергей Тараканов, отметив, что даже взрыв в непосредственной близости